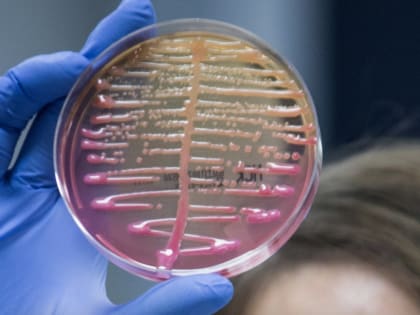
Условно-патогенный представитель бактерий группы кишечной палочки (БГКП)

Здоровье

Неликвидированные свалки на сельхозземлях ведут к риску распространения гриппа птиц
Незаконное складирование отходов на землях сельскохозяйственного назначения наносит не только огромный вред экологии и ущерб почвам, является источником природных пожаров, но и способствует распространению опасных болезней.

Ростовская АЭС запустила акцию по сбору детских рисунков для оформления интерьеров больниц региона
Девятый год подряд Ростовская АЭС проводит благотворительную акцию «От сердца к сердцу», в рамках которой собирает детские рисунки, оформляет их и передает в дар медучреждениям региона.

В Ростовской области животных начнут прививать от бешенства «вкусной» вакциной
На территории Ростовской области диких животных начнут прививать от бешенства «вкусной» вакциной.

Подтверждена польза травяного чая для женского здоровья
Группа британских врачей общей практики и нутрициологов провела обзор данных, полученных в ходе девяти клинических исследований.

Разнообразие чая
Столь простой и привычный каждому человеку продукт как чай имеет внушительную и невероятно интересную историю, которая уходит своими корнями вглубь древности.
Условно-патогенный представитель бактерий группы кишечной палочки (БГКП)
К условно-патогенным микроорганизмам относятся Клебсиеллы (семейство Энтеробактерий), в свою очередь относящиеся к Бактериям группы кишечной палочки (БГКП).

Проводится набор на курс занятий для желающих бросить курить
С 30 мая стартует программа - «Бездымная жизнь». Это социальный проект ГБУ РО «Наркологический диспансер» и Донской публичной библиотеки при поддержке Министерства здравоохранения Ростовской области,

Россиянам назвали оптимальную частоту мытья рук
Регулярное мытье рук поможет избежать развития кишечных инфекций и снизит риск заболевания ОРВИ, гриппом и другими инфекционными заболеваниями.

В поликлиниках Ростовской области появятся психологи
Ростовская область, 23 мая 2023. DON24.RU. Жители Ростовской области смогут обращаться за психологической помощью в поликлиники, сообщили в пресс-службе регионального Росздравнадзора.

Как укрепить иммунитет, чтобы он мог дать отпор любому вирусу?
Как укрепить иммунитет, чтобы он мог дать отпор любому вирусу? Как позаботиться об организме изнутри?